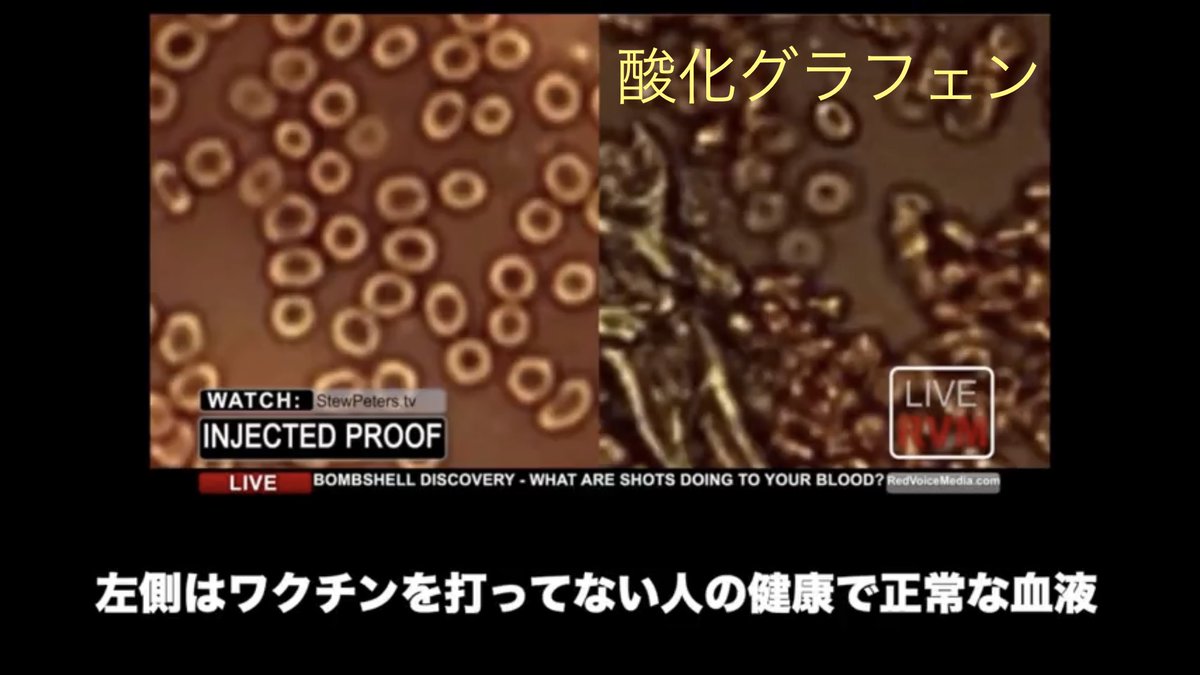

201
自衛隊のパワハラしゃれにならん。昔の悪しき習慣を今日まで放置してきた政治家達の責任は重い。世襲の無能議員達も自衛隊の反社上官達も総入れ替えして、立て直さなければ国が滅ぶ。何か日本国民の目を覚まさせる手はないのだろうか。
203
飼い主が愛犬にチューすると…🥰
204
情報の共有ありがとうございます。自分が打って安心してるなら他者のことは放っておけばよいのに、非接種者を見つけては同調圧力をかけ、攻撃する病的な者達がなんと多いことか。死亡率0%の子ども達にまで危険な爆沈を打つなんて、もはや思考停止ではなく思考力そのものがないとしか思えません。 twitter.com/QDh5YYLxhUU5v0…
205
アメリカのABCニュースがFBで「爆沈を打たなかったせいで家族が亡くなった人いましたら取材させて下さい」と投稿したところ「打ったせいで苦しんで死んだ人なら知ってるぜ」といった反対の意見が殺到。印象操作しようとするマスゴミを国民が返り討ちにしたワケだ。ざまぁ😇
m.facebook.com/wxyzdetroit/ph…
206
今日も私は、要もないし急いでもないけど外に出て、日光を浴び、新鮮な空気を吸い、友達と話してHAHAと笑い、筋トレして、低糖質・高タンパクな食事を摂って、帰宅したらアルコールでスマホ消毒して、純石けんで手洗いして、免疫力MAXで爆烈健康に生きてまーす😇
207
🐑「打ってない奴らが感染を拡大させているんだ!ゲホッ」
🐼「大丈夫ですか?打ってない私よりあなたの方が呼吸器系に問題ありそうですけど」
🐑「いや、これはマスクをしてるから、ゲホゲホッ」
🐼「大丈夫ですか?マスクしてない私よりあなたの方が感染症の症状出てますけど」
🐑「ゲフォッ!」
208
皆さまのおかげで私のSNSはわりと平和ですが、同じような活動をしてる方達のページを見ると工作員達がわらわら湧いており、常にどこかで言い争いが起きています。絡まれた経験のある方も多いのではないでしょうか。後ほど私なりの対処法をシェアしますので、ぜひ実践してもらえたらと思います😌
211
212
本来は暑さが終わって嬉しいはずの季節が地獄の訪れに感じる。これほど自分の予想がハズれてほしいと思ったことはない。私はここ最近のシープルからの攻撃ツイートを見て確信した。彼らはおそらくこれから起こる大惨事でも目が覚めない。命が懸かった「認知的不協和」は強烈なバイアスがはたらくのだ。
213
- 正常性バイアス
異常事態に直面した時、落ち着くために補整する。「まさか、自分だけは大丈夫だろう」
- 確証バイアス
自分の支持する情報だけを集め、反する情報は探そうとしない。「都合の悪い真実はデマ、陰謀論」
- バンドワゴン効果
多数派に流される。「みんながやってるから正しい」
214
- ミルグラム効果
権威への服従。「政府やメディアが言ってるのだから正しい」
- コンコルド錯誤
これまで投資した分を惜しみ、ダメだとわかってても続けてしまう。「後に引けない」
- コミットメントと一貫性
一度表明した立場を変えることは難しい。「後に引けない」
215
ワクチンから寄生虫が見つかる / イベルメクチンが効く理由 hellomitz3.net/?p=3614
216
連中の手口はこちらを参考にして頂きたい
hellomitz3.net/?p=2768
217
218
こういった世の中のウソ常識を教えてくれる数少ない先生方こそ本物の医者よ。以前やりましたが、糖質制限してコレステロール値が高くなっても中性脂肪が下がっていれば問題ないというのはまさにこういうことです。コレステロールは血管を修復するためのもの。降下薬の服用は自傷行為です😌 twitter.com/fhljpt/status/…
221
コロナ茶番では悲劇にばかり目が行ってしまうが、良い方に目を向ければ、私のフォロワーの医師の先生方をはじめ、多くの良心的な先生達をSNSでお見かけした。コロナ茶番はエセ専門家・エリートシープルを炙り出したが、同時に、ちゃんと論理的思考ができる本物のエリートを判別する篩にもなった。
222
爆沈キャンペーンを行った、もれなく全ての国で感染爆発が起こってるワケだが、これさえも「因果関係は不明」で済まされるのか。偶然なワケねぇだろ😇
224
225
テレビには御用学者ばかりが出演します。なぜだかわかりますか?反対派と呼ばれる本物の専門家達と討論番組でもやろうもんなら、徹底的に論破されて視聴者にウソがバレてしまうからです。もし自分達が本当に正しいなら、デマ・陰謀論を潰す絶好の機会になるのに絶対に討論しません。ウソだからです。